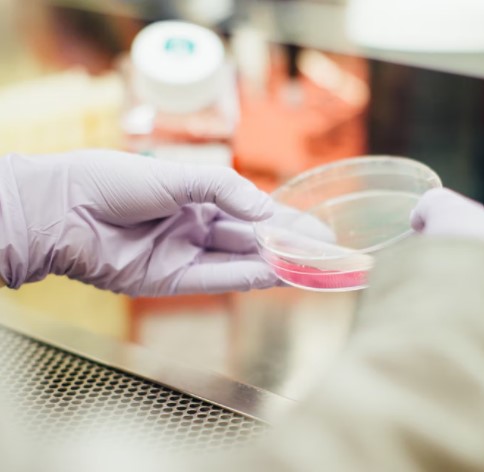

Lo hemos visto antes: gemelos que crecen en dos familias diferentes sin saber que existían. Es un escenario tan alucinante que no es de extrañar que haya sido la trama de películas y programas de televisión.
Pero Molly Sinert descubrió que estaba viviendo este escenario que parecía ficticio como una realidad, y todo fue gracias a algunos resultados de ADN confusos.


Molly nació en Corea del Sur y fue adoptada por una familia estadounidense que creció en Florida.
No sabía que a varios miles de kilómetros de distancia, también en Estados Unidos, su hermana gemela idéntica, Emily Bushnell, estaba creciendo en Filadelfia.


Emily y Molly experimentaron sus propias y hermosas infancias, ninguna de las dos tenía idea de que tenían un hermana, y mucho menos una gemela.


Fue simplemente cuando la hija de 11 años de Emily la presionó para que investigara su ascendencia que todo se reveló.
En una entrevista de ABC News, Isabel, la hija de Emily, explicó:
“Quería hacer la prueba de ADN porque ella era adoptada. Quería saber si tenía más familiares de sangre”.


A Emily no le gustó la idea de hacerse la prueba de ADN, así que dejó que Isabel se la hiciera, sabiendo que aún recibiría muchas respuestas de su hija.
En un giro del destino, Isabel recibió sus resultados casi al mismo tiempo que Molly, en Florida, quien también se había hecho una prueba de ADN.
Al principio, fue un poco desconcertante, ya que predijo que Molly tendría una hija.


Molly estaba confundida inicialmente, preguntándose si la prueba de ADN podría haber sido defectuosa. Ella recordó:
“Hice clic en el pariente cercano y no lo entendí. [Decía] ‘usted comparte 49.96% de ADN con esta persona. Predecimos que ella es su hija’. Esto obviamente no es correcto, porque nunca he entrado en trabajo de parto, no tengo hijos”.

Pero una vez que se enteró de la noticia, Molly se dio cuenta de que no tenía una hija… ¡tenía una gemela idéntica!
Esto se confirmó cuando se puso en contacto con Isabel en el sitio web de pruebas de ADN, con curiosidad por saber cuál podría ser su relación con su coincidencia del 49,96%.


Cuando Isabel respondió con una breve explicación de la historia de su madre y su fecha de nacimiento, se confirmó: Molly estaba hablando con la hija de su hermana gemela.
Con ese conocimiento, dijo, “se llenó de inmediato un vacío en mi corazón”.
Ella añadió:
“Aunque tengo familiares que me aman y me adoran y han sido absolutamente maravillosos, siempre hubo una sensación de desconexión. Descubrir que tenía una hermana gemela idéntica hizo que todo quedara muy claro. Todo tiene sentido”.


Las gemelas pronto se pusieron en contacto y no pasó mucho tiempo hasta que descubrieron que, aunque habían llevado vidas separadas, había muchos aspectos similares de su infancia que algunos compararían con el “instinto gemelo”.
Por ejemplo, en sus bailes de graduación separados de la escuela secundaria, ambos gemelos usaron vestidos de cuentas con collares de estilo similar y peinados casi idénticos.


La pareja quería desesperadamente estar más cerca, pero se abstuvieron de chatear por video.
Ambas sabían que sería más especial conocerse en persona.
Y eso es exactamente lo que hicieron en su 36 cumpleaños, en una ocasión que ninguna de las dos olvidará.


Incluso hasta el día de hoy, 36 años después, Molly y Emily no tienen idea del por qué fueron separadas al nacer y luego adoptadas por familias estadounidenses.


Como resultado, la sección de comentarios tuvo una oportunidad con las agencias de adopción.
“Sé que estas reuniones son agridulces, pero realmente odio que las agencias de adopción separen a los hermanos, y mucho menos a los gemelos. Es algo horrible de hacer”.
Dice un espectador, mientras que otro comenta,
“Realmente desearía que las agencias de adopción fueran más sinceras con las familias adoptivas sobre los hermanos conocidos. Es simplemente cruel separar a los gemelos”.


Aún así, esto hizo que la reunión fuera maravillosa. Esa misteriosa “cosa gemela” jugó para estos dos.
Aunque no pudieron compartir la misma infancia juntas, gracias a Dios que estas hermanas se encontraron y pueden crear muchos recuerdos hermosos en el futuro.
¡Mira el video a continuación para que veas más sobre esta increíble historia!
Por favor COMPARTE esto con tus amigos y familiares.
